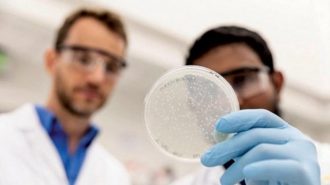

- اخر الاخبار
- امن
-
- اقتصادية
تابعنا على Facebook
RSS FEED الملقم الاخباري
-
أنتقل الى
تواصل معنا
صحة و جمال
طريقة للكشف عن سرطان الدم في مرحلة مبكرة
قالت طبيبة أمراض الدم، يوليا نيناشيفا إن ارتفاع نسبة الهيموغلوبين وارتفاع كريات الدم الحمراء يمثلان سببا لاستشارة طبيب أمراض الدم، فقد تشير هذه الأعراض إلى مرض سرطان الدم. وأكدت الطبيبة أن المستوى العالي من الصفائح الدموية وخلايا الدم البيضاء يشير أيضا إلى هذا المرض. وقالت للقناة الخامسة الروسية: “انخفاض عدد الكريات البيضاء لا يؤثر على المزيد
منشط جنسي.. 7 فوائد مذهلة لخشب الصندل الأحمر
يتمتع نبات خشب الصندل الأحمر، واسمه العلمي Pterocarpus santalinus L، بقدرة علاجية مذهلة في العديد من الاستخدامات. وعرض موقع ” boldsky” الفوائد المذهلة لنبات خشب الصندل الأحمر، وهو مشهور المزيد
دراسة مفاجئة عن كورونا: الحرارة تحجمه ولا تقضي عليه
توصلت دراسة جديدة إلى أن درجات الحرارة الدافئة والمناخ المداري قد يساعد حقًا في الحد من انتشار فيروس كورونا المستجد (كوفيد -19). ووجدت الدراسة التي أجراها باحثون من معهد المزيد
لمرضى السكري.. 10 فوائد للخس
يعتبر “الخس” بأنواعه أحد أفضل الأطعمة التي تساعد على الشعور بالشبع لذلك يفضله الكثير من متبعي الحميات الغذائية. يحتوي “الخس” على عناصر غذائية أساسية مثل حمض الفوليك، والفيتامينات (A، المزيد
مختصون يكشفون عن عادات تحول دون انقاص الوزن
كشفت الأخصائية الروسية في التغذية، إيرينا بيساريفا، عن العادات السيئة التي تمنع انقاص وزن الانسان البدين. وبحسب الأخصائية، أولا وقبل كل شيء، يجب على المرء أن يتخلى عن نمط المزيد
اكتشاف بروتين داخل أجسام البشر يحمي من سرطان قاتل
نجح فريق بحثي في التوصل إلى بروتين داخل أجسام البشر، يحمي من الإصابة بنوع قاتل من السرطانات. اكتشف باحثون في جامعة فلوريدا، وجود بروتين داخل الجسم يعمل على الحماية المزيد
كيف تحافظ على مناعة جسمك قوية حتى نهاية رمضان
قدمت خبيرة تغذية مجموعة من النصائح التي تساعد الصائم في الحفاظ على جهازه المناعي قويا حتى نهاية شهر رمضان. ودعت اختصاصية التغذية، داليا حرب، إلى تناول النشويات المعقدة كالبقوليات المزيد
الجسم يحتاج الى 9 ساعات من النوم العميق
يتم طرح كلمات مثل النوم العميق وحركة العين السريعة بشكل عرضي هذه الأيام مع اختراع ساعات تتبع الصحة التي تخبرنا بمعلومات مفصلة عن نومنا. إذن ما هو النوم العميق، المزيد
دراسة جديدة تكشف ما الذي يفعله اعتياد شرب القهوة في الدماغ
رصدت دراسة جديدة مثيرة نشاط الدماغ لاكتشاف كيف تؤثر القهوة على اتصال الدماغ بطرق لم يتم دراستها عن كثب من قبل. وقاد اختصاصي الأشعة العصبية نونو سوزا، رئيس كلية المزيد
أنواع من التمور تناسب مرضى السكري.. حقيقة أم شائعة
هل هناك أنواع معينة من التمور تعتبر مناسبة لمرضى السكري نظرا لاحتوائها على مستويات منخفضة من السكريات؟. الهيئة العامة للغذاء والدواء السعودية، قالت إن الحديث يدور عن شائعة جرى المزيد